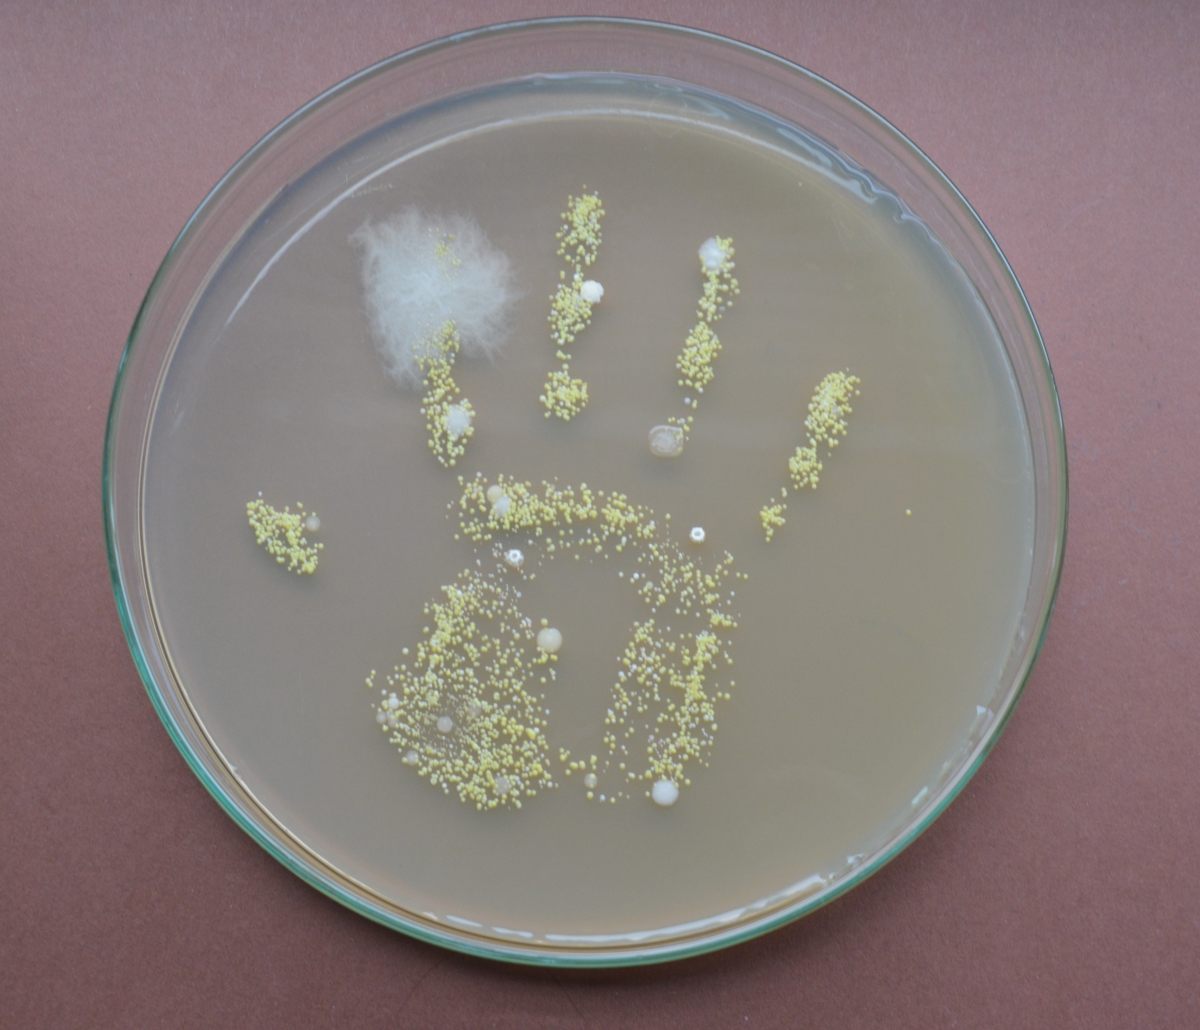

Mikrobiom
Fachgruppensprecher

Helmholtz Zentrum München
Dt. Forschungszentrum für Gesundheit und Umwelt/ Comparative Microbiome Analysis
TU München/ Umweltmikrobiologie
Ingolstädter Landstraße 1
85764 Neuherberg
schloter@helmholtz-munich.de
Stellvertretende Sprecherin

Medizinische Universität Graz
Diagnostik- und Forschungsinstitut für Hygiene, Mikrobiologie und Umweltmedizin
Neue Stiftingtalstraße 6
8010 Graz
christine.moissl-eichinger@medunigraz.at
Die Analyse von Mikrobiomen ist eines der im Moment am dynamischsten wachsenden Forschungsfelder weltweit. Neben neuen Erkenntnissen zu wichtigen grundlegenden Fragen, insbesondere dazu, welche Faktoren die Struktur und Funktionalität von Mikrobiomen beeinflussen, gibt es eine Reihe vielversprechender angewandter Forschungsarbeiten in den Bereichen Landwirtschaft, Biotechnologie und Medizin. Hier werden auf der Basis neuester Daten Applikationen entwickelt, um damit gezielt unsere Gesundheit und die unserer Umwelt zu verbessern. An diesen Arbeiten sind maßgeblich auch Forschende beteiligt, die Mitglied der VAAM sind.
Die Etablierung der Fachgruppe für Mikrobiomforschung soll die Sichtbarkeit der Mikrobiomforschung in Deutschland, Österreich und der Schweiz verbessern und eine Plattform bieten, um gemeinsame Forschungsvorhaben zu entwickeln. Eine enge Zusammenarbeit mit der DGHM wird angestrebt.